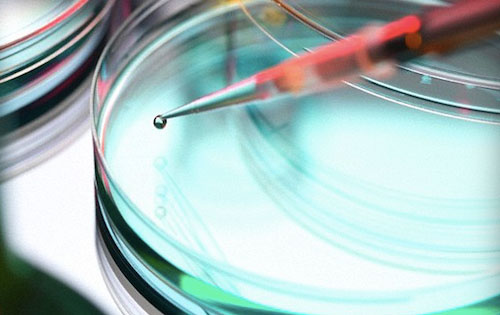
美國研究發(fā)現(xiàn)葡萄酒能預防及對抗結腸癌

(新聞來源:樂酒客lookvin)
BMC旗下醫(yī)學雜志《Complementary and Alternative Medicine》(補充和代替醫(yī)療)刊登了美國賓夕法尼亞大學的最新研究成果:葡萄酒能預防及對抗結腸癌。
結腸癌是美國第三大常見癌癥,也是致死率位居第二的癌癥,賓州大學研究人員分別測試了白藜蘆醇和葡萄籽萃取物對患癌白鼠以及人體干細胞的作用。
對白藜蘆醇的研究比較普遍,但同時補充葡萄籽原花青素還是新領域。研究論文第一作者、賓州大學食品科學系助理教授Jairam Vanamala博士稱:“單獨而論,白藜蘆醇和葡萄籽原花青素都不是特別有效,但二者結合就取得了效果。”
研究的另一個關鍵方面在于:將這些葡萄中所含的化合物與舒林酸(歐洲用于結腸癌化療的常用消炎藥)藥物進行對比。舒林酸固然藥效顯著,但能引起腸道出血。“因此我們想知道葡萄所含的化合物是否能抑制腫瘤,同時還沒有舒林酸的副作用。”
研究人員將52只患癌白鼠分成四組分別注射,一組為控制組,一組注射舒林酸,兩組注射不同劑量的白藜蘆醇和葡萄籽提取物。
在培養(yǎng)皿進行的人體干細胞測試也分成兩部分,一個注入舒林酸,一個注入白藜蘆醇和葡萄籽提取物。
最終結果顯示,接受葡萄化合物注射的白鼠中,腫瘤得到抑制的達50%以上。注射舒林酸的白鼠小組結果差不多,但均產(chǎn)生嚙齒類動物潰瘍癥狀。
培養(yǎng)皿實驗顯示,暴露于葡萄化合物環(huán)境中的結腸癌細胞生長能力有限。
Vanamala博士稱,進食水果、蔬菜為主的人罹患結腸癌的幾率比較低。“食療”是最安全、成本最低的防癌、抗癌方式。雖然這些還需要更深入的研究,但本文的研究顯然證實了葡萄籽提取物和白藜蘆醇在化療方面具有很大潛力。